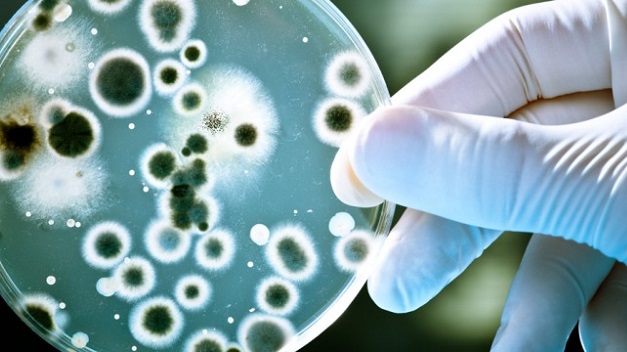

La Dra. Graciela Valbuena posee más de 25 años de trayectoria en micología, a través de la cual se ha constituido en una referencia diagnóstica para varios médicos Dermatólogos de nuestra región.
Tiene vasta experiencia en la evaluación de lesiones micóticas, toma de muestras, cultivo, identificación bioquímica/morfológica y determinación de sensibilidad/resistencia de los hongos a antimicóticos específicos.
Es importante destacar que la resolución de un estudio micológico puede demorar entre dos semanas y dos meses, según el tipo de muestra y lo “fastidioso” del hongo en cultivo. Dado que las lesiones suelen progresar con lentitud, la demora en el resultado habitualmente no genera un problema terapéutico. Sin embargo, ante cualquier duda consulte a su médico.Las tomas de muestra requieren una preparación previa de la zona de lesión, y son indefectiblemente con turno previo. Por favor llame por teléfono al Laboratorio para solicitar su turno, le detallaremos la preparación requerida para la toma de muestra, y requerimientos administrativos para la autorización de la orden.